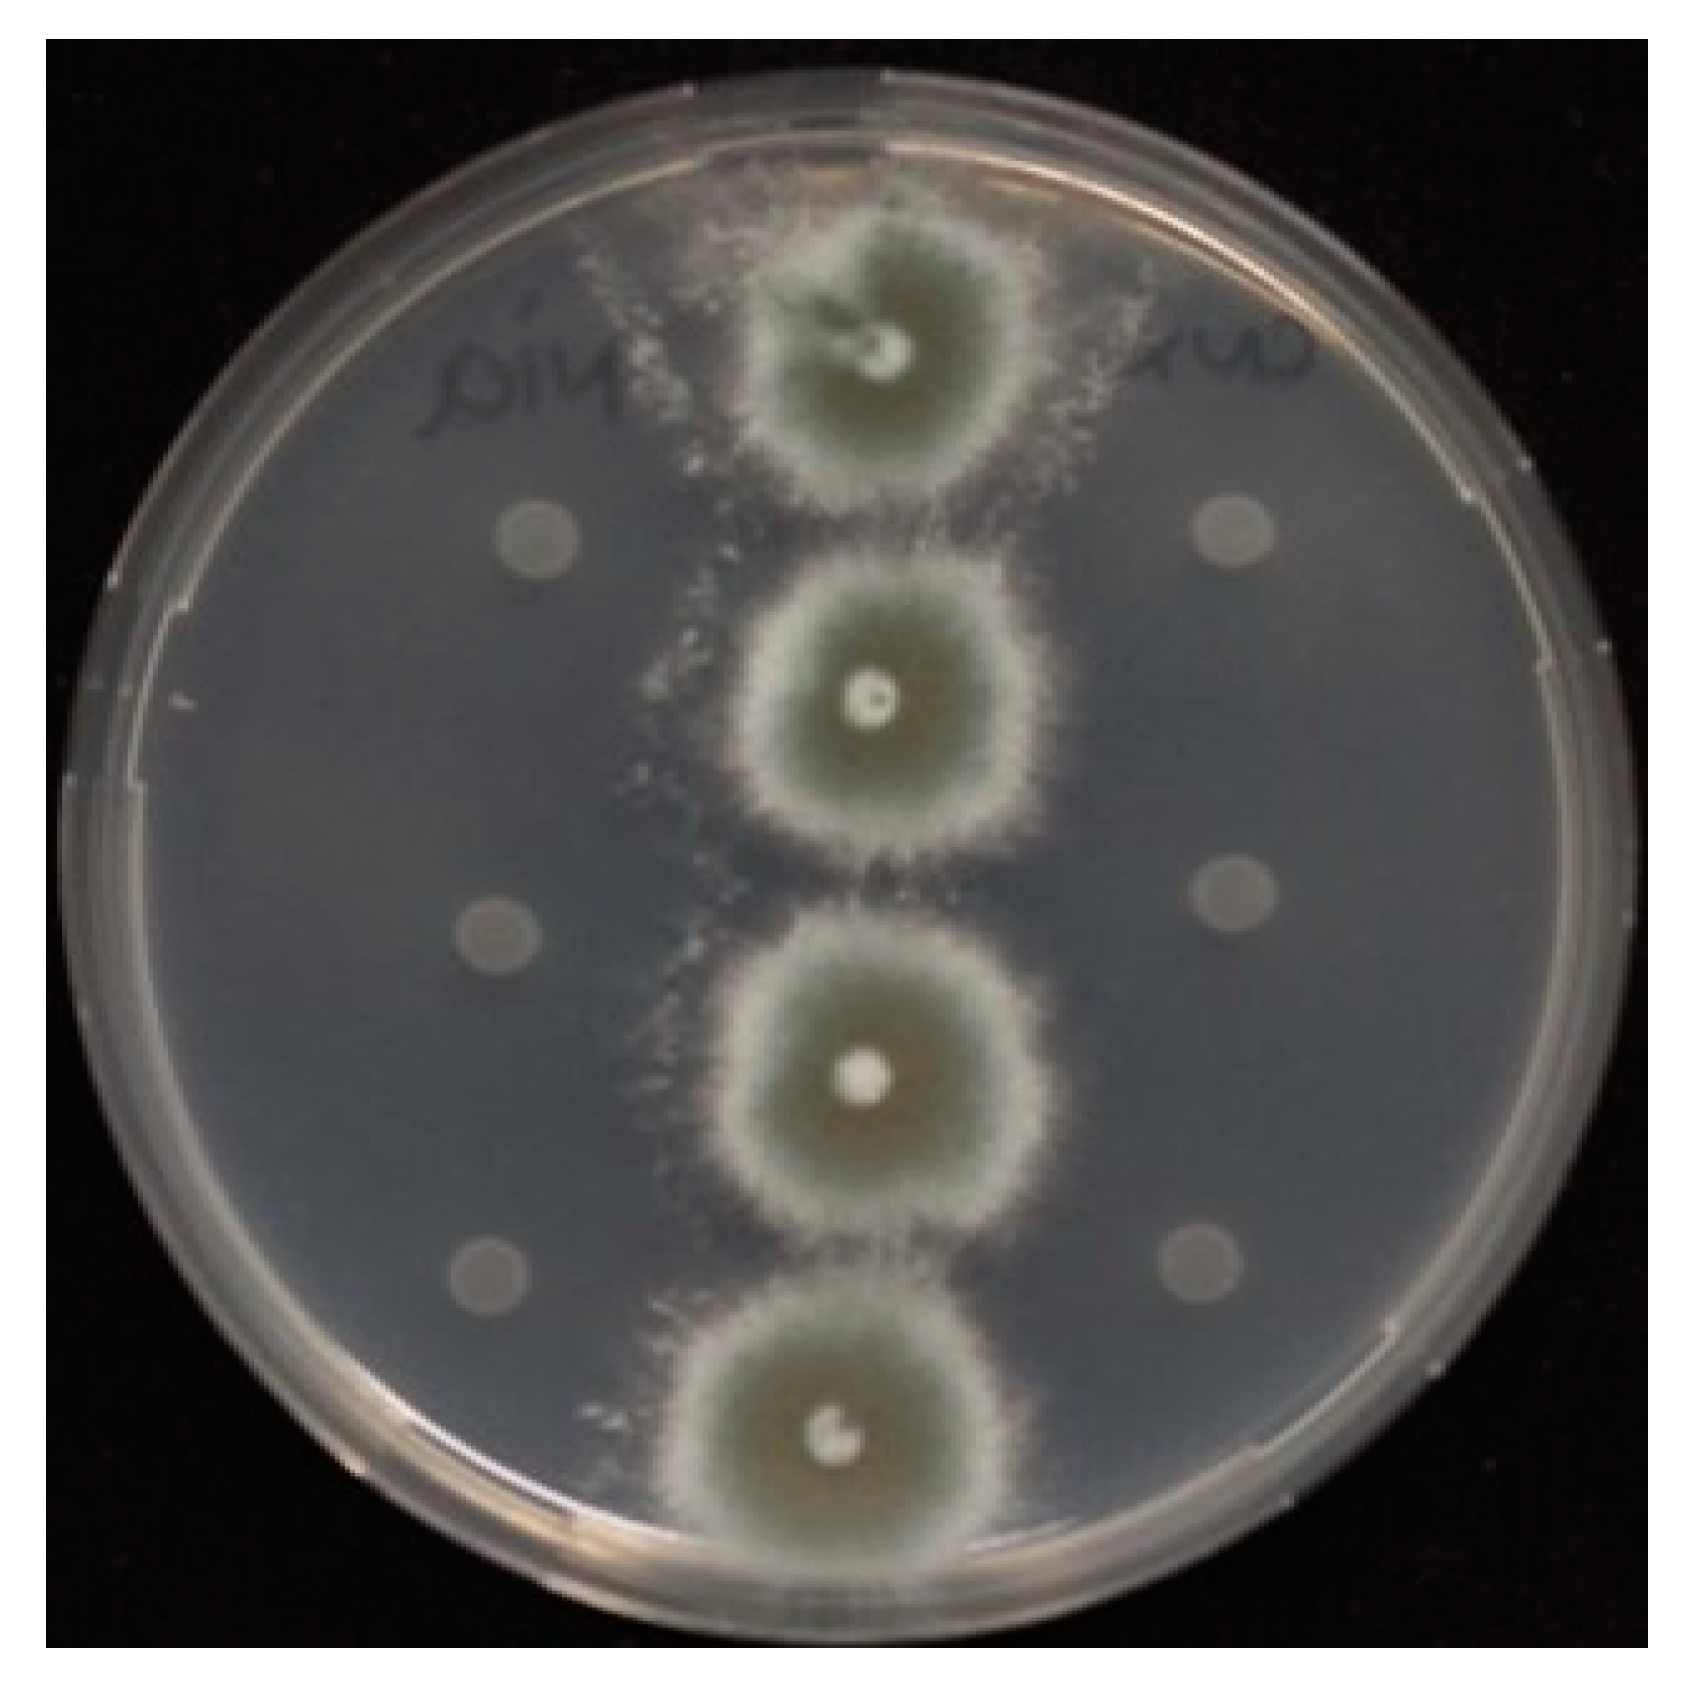
Jof 06 00277 g002

The Medical Triazole Voriconazole Can Select for Tandem Repeat Variations in Azole-Resistant Aspergillus Fumigatus Harboring TR34/L98H Via Asexual Reproduction
Abstract
1. Introduction
2. Materials and Methods
3. Results
3.1. Evolution of Azole Resistance
3.2. The Ancestor TR34/L98H and Evolved TR343/L98H Are Isogenic
3.3. Susceptibility Testing and Cyp51a Gene Expression of Ancestor and Evolved Isolates
3.4. The Role of SNPs in the Observed Azole-Resistant Phenotypes
3.5. The Mycelium Growth Rate and Conidia Production of Ancestor and Evolved TR34 Genotypes
3.6. Competition between TR34/L98H and TR343/L98H
4. Discussion
Supplementary Materials
Author Contributions
Funding
Acknowledgments
Conflicts of Interest
References
- Buil, J.B.; Snelders, E.; Denardi, L.B.; Melchers, W.J.; Verweij, P.E. Trends in Azole Resistance in Aspergillus fumigatus, the Netherlands, 1994–2016. Emerg. Infect. Dis. 2019, 25, 176. [Google Scholar] [CrossRef] [PubMed]
- Snelders, E.; Van der Lee, H.A.; Kuijpers, J.; Rijs, A.J.M.; Varga, J.; Samson, R.A.; Mellado, E.; Donders, A.R.T.; Melchers, W.J.; Verweij, P.E. Emergence of azole resistance in Aspergillus fumigatus and spread of a single resistance mechanism. PLoS Med. 2008, 5, e219. [Google Scholar] [CrossRef] [PubMed]
- Vermeulen, E.; Lagrou, K.; Verweij, P.E. Azole resistance in Aspergillus fumigatus: A growing public health concern. Curr. Opin. Infect. Dis. 2013, 26, 493–500. [Google Scholar] [CrossRef] [PubMed]
- Zhang, J.; Snelders, E.; Zwaan, B.J.; Schoustra, S.E.; Meis, J.F.; van Dijk, K.; Hagen, F.; Van der Beek, M.T.; Kampinga, G.A.; Zoll, J.; et al. A Novel Environmental Azole Resistance Mutation in Aspergillus fumigatus and a Possible Role of Sexual Reproduction in Its Emergence. mBio 2017, 8. [Google Scholar] [CrossRef] [PubMed]
- Hare, R.K.; Gertsen, J.B.; Astvad, K.M.; Degn, K.B.; Løkke, A.; Stegger, M.; Andersen, P.S.; Kristensen, L.; Arendrup, M.C. In Vivo Selection of a Unique Tandem Repeat Mediated Azole Resistance Mechanism (TR120) in Aspergillus fumigatus cyp51A, Denmark. Emerg. Infect. Dis. 2019, 25, 577. [Google Scholar] [CrossRef] [PubMed]
- Sijmen, E.S.; Alfons, J.M.D.; Antonius, J.M.M.R.; Jianhua, Z.; Eveline, S.; Peter, C.L.; Willem, J.G.M.; Anton, G.R.; Bas, J.Z.; Paul, E.V. Environmental Hotspots for Azole Resistance Selection of Aspergillus fumigatus, the Netherlands. Emerg. Infect. Dis. J. 2019, 25. [Google Scholar] [CrossRef]
- Snelders, E.; Camps, S.M.; Karawajczyk, A.; Schaftenaar, G.; Kema, G.H.; van der Lee, H.A.; Klaassen, C.H.; Melchers, W.J.; Verweij, P.E. Triazole fungicides can induce cross-resistance to medical triazoles in Aspergillus fumigatus. PLoS ONE 2012, 7, e31801. [Google Scholar] [CrossRef]
- Zhang, J.; van den Heuvel, J.; Debets, A.J.M.; Verweij, P.E.; Melchers, W.J.G.; Zwaan, B.J.; Schoustra, S.E. Evolution of cross-resistance to medical triazoles in Aspergillus fumigatus through selection pressure of environmental fungicides. Proc. R. Soc. B Biol. Sci. 2017, 284. [Google Scholar] [CrossRef]
- Risum, M.; Hare, R.K.; Gertsen, J.B.; Kristensen, L.; Johansen, H.K.; Helweg-Larsen, J.; Abou-Chakra, N.; Pressler, T.; Skov, M.; Jensen-Fangel, S.; et al. Azole-Resistant Aspergillus fumigatus Among Danish Cystic Fibrosis Patients: Increasing Prevalence and Dominance of TR34/L98H. Front. Microbiol. 2020, 11. [Google Scholar] [CrossRef]
- Buil, J.B.; Hare, R.K.; Zwaan, B.J.; Arendrup, M.C.; Melchers, W.J.G.; Verweij, P.E. The fading boundaries between patient and environmental routes of triazole resistance selection in Aspergillus fumigatus. PLoS Pathog. 2019, 15, e1007858. [Google Scholar] [CrossRef]
- Pieter, P.A.L.; Jochem, B.B.; Martha, T.v.d.B.; Karin van, D.; Greetje, A.K.; Bart, J.A.R.; Alieke, G.V.; Sabine, C.d.G.; Annelot, F.S.; Jaap van, D.; et al. Paradoxal Trends in Azole-Resistant Aspergillus fumigatus in a National Multicenter Surveillance Program, 2013–2018. Emerg. Infect. Dis. J. 2020, 26. [Google Scholar] [CrossRef]
- Alvarez-Moreno, C.; Lavergne, R.-A.; Hagen, F.; Morio, F.; Meis, J.F.; Le Pape, P. Azole-resistant Aspergillus fumigatus harboring TR34/L98H, TR46/Y121F/T289A and TR53 mutations related to flower fields in Colombia. Sci. Rep. 2017, 7. [Google Scholar] [CrossRef] [PubMed]
- Camps, S.M.; Rijs, A.J.; Klaassen, C.H.; Meis, J.F.; O’Gorman, C.M.; Dyer, P.S.; Melchers, W.J.; Verweij, P.E. Molecular Epidemiology of Aspergillus fumigatus Isolates Harboring the TR34/L98H Azole Resistance Mechanism. J. Clin. Microbiol. 2012, 50, 2674–2680. [Google Scholar] [CrossRef] [PubMed]
- Gsaller, F.; Hortschansky, P.; Furukawa, T.; Carr, P.D.; Rash, B.; Capilla, J.; Müller, C.; Bracher, F.; Bowyer, P.; Haas, H.; et al. Sterol Biosynthesis and Azole Tolerance Is Governed by the Opposing Actions of SrbA and the CCAAT Binding Complex. PLoS Pathog. 2016, 12, e1005775. [Google Scholar] [CrossRef]
- Haber, J.E.; Louis, E.J. Minisatellite Origins in Yeast and Humans. Genomics 1998, 48, 132–135. [Google Scholar] [CrossRef]
- Kadyk, L.C.; Hartwell, L.H. Sister chromatids are preferred over homologs as substrates for recombinational repair in Saccharomyces cerevisiae. Genetics 1992, 132, 387–402. [Google Scholar]
- Schoustra, S.E.; Debets, A.J.; Slakhorst, M.; Hoekstra, R.F. Mitotic recombination accelerates adaptation in the fungus Aspergillus nidulans. PLoS Genet. 2007, 3, e68. [Google Scholar] [CrossRef]
- Zhang, J.; Debets, A.J.; Verweij, P.E.; Melchers, W.J.; Zwaan, B.J.; Schoustra, S.E. Asexual sporulation facilitates adaptation: The emergence of azole resistance in Aspergillus fumigatus. Evolution 2015, 69, 2573–2586. [Google Scholar] [CrossRef]
- Ballard, E.; Zoll, J.; Melchers, W.J.; Brown, A.J.; Warris, A.; Verweij, P.E. Raw genome sequence data for 13 isogenic Aspergillus fumigatus strains isolated over a 2 year period from a patient with chronic granulomatous disease. Data Brief 2019, 104021. [Google Scholar] [CrossRef]
- Mellado, E.; Garcia-Effron, G.; Alcazar-Fuoli, L.; Cuenca-Estrella, M.; Rodriguez-Tudela, J. Substitutions at methionine 220 in the 14α-sterol demethylase (Cyp51A) of Aspergillus fumigatus are responsible for resistance in vitro to azole antifungal drugs. Antimicrob. Agents Chemother. 2004, 48, 2747–2750. [Google Scholar] [CrossRef]
- Mellado, E.; Garcia-Effron, G.; Alcazar-Fuoli, L.; Melchers, W.J.; Verweij, P.E.; Cuenca-Estrella, M.; Rodriguez-Tudela, J.L. A new Aspergillus fumigatus resistance mechanism conferring in vitro cross-resistance to azole antifungals involves a combination of cyp51A alterations. Antimicrob. Agents Chemother. 2007, 51, 1897–1904. [Google Scholar] [CrossRef] [PubMed]
- Glass, N.L.; Kuldau, G.A. Mating type and vegetative incompatibility in filamentous ascomycetes. Annu. Rev. Phytopathol. 1992, 30, 201–224. [Google Scholar] [CrossRef] [PubMed]
- Aanen, D.; Debets, A.J.M.; Glass, N.L.; Saupe, S.J. Biology and genetics of vegetative incompatibility in fungi. In Cellular and Molecular Biology of Filamentous Fungi; Borkovich, K., Ebbole, D., Eds.; American Society of Microbiology: Washington, DC, USA, 2010; pp. 274–288. [Google Scholar] [CrossRef]
- Cove, D. Chlorate toxicity in Aspergillus nidulans: The selection and characterization of chlorate resistant mutants. Heredity 1976, 36, 191–203. [Google Scholar] [CrossRef] [PubMed]
- Debets, A.J.; Swart, K.; Bos, C.J. Genetic analysis of Aspergillus niger: Isolation of chlorate resistance mutants, their use in mitotic mapping and evidence for an eighth linkage group. Mol. Gen. Genet. MGG 1990, 221, 453–458. [Google Scholar] [CrossRef]
- Todd, R.B.; Davis, M.A.; Hynes, M.J. Genetic manipulation of Aspergillus nidulans: Heterokaryons and diploids for dominance, complementation and haploidization analyses. Nat. Protoc. 2007, 2, 822–830. [Google Scholar] [CrossRef]
- Zhang, J.; Snelders, E.E.; Zwaan, B.J.; Schoustra, S.E.; Kuijper, E.J.; Arendrup, M.C.; Melchers, W.J.; Verweij, P.E.; Debets, A.J. Relevance of heterokaryosis for adaptation and azole-resistance development in Aspergillus fumigatus. Proc. R. Soc. B 2019, 286, 20182886. [Google Scholar] [CrossRef]
- Bolger, A.M.; Lohse, M.; Usadel, B. Trimmomatic: A flexible trimmer for Illumina sequence data. Bioinformatics 2014, 30, 2114–2120. [Google Scholar] [CrossRef]
- Li, H. Aligning sequence reads, clone sequences and assembly contigs with BWA-MEM. arXiv 2013, arXiv:1303.3997. [Google Scholar]
- Li, H.; Handsaker, B.; Wysoker, A.; Fennell, T.; Ruan, J.; Homer, N.; Marth, G.; Abecasis, G.; Durbin, R. The sequence alignment/map format and SAMtools. Bioinformatics 2009, 25, 2078–2079. [Google Scholar] [CrossRef]
- McKenna, A.; Hanna, M.; Banks, E.; Sivachenko, A.; Cibulskis, K.; Kernytsky, A.; Garimella, K.; Altshuler, D.; Gabriel, S.; Daly, M. The Genome Analysis Toolkit: A MapReduce framework for analyzing next-generation DNA sequencing data. Genome Res. 2010, 20, 1297–1303. [Google Scholar] [CrossRef]
- Koboldt, D.C.; Chen, K.; Wylie, T.; Larson, D.E.; McLellan, M.D.; Mardis, E.R.; Weinstock, G.M.; Wilson, R.K.; Ding, L. VarScan: Variant detection in massively parallel sequencing of individual and pooled samples. Bioinformatics 2009, 25, 2283–2285. [Google Scholar] [CrossRef] [PubMed]
- Knaus, B.J.; Grünwald, N.J. vcfr: A package to manipulate and visualize variant call format data in R. Mol. Ecol. Resour. 2017, 17, 44–53. [Google Scholar] [CrossRef] [PubMed]
- Robinson, J.T.; Thorvaldsdóttir, H.; Winckler, W.; Guttman, M.; Lander, E.S.; Getz, G.; Mesirov, J.P. Integrative genomics viewer. Nat. Biotechnol. 2011, 29, 24. [Google Scholar] [CrossRef] [PubMed]
- Livak, K.J.; Schmittgen, T.D. Analysis of relative gene expression data using real-time quantitative PCR and the 2−ΔΔCT method. Methods 2001, 25, 402–408. [Google Scholar] [CrossRef] [PubMed]
- Hagiwara, D.; Miura, D.; Shimizu, K.; Paul, S.; Ohba, A.; Gonoi, T.; Watanabe, A.; Kamei, K.; Shintani, T.; Moye-Rowley, W.S.; et al. A Novel Zn2-Cys6 Transcription Factor AtrR Plays a Key Role in an Azole Resistance Mechanism of Aspergillus fumigatus by Co-regulating cyp51A and cdr1B Expressions. PLoS Pathog. 2017, 13, e1006096. [Google Scholar] [CrossRef]
- Tartof, K.D. Unequal Mitotic Sister Chromatid Exchange as the Mechanism of Ribosomal RNA Gene Magnification. Proc. Natl. Acad. Sci. USA 1974, 71, 1272–1276. [Google Scholar] [CrossRef]
- Levinson, G.; Gutman, G.A. Slipped-strand mispairing: A major mechanism for DNA sequence evolution. Mol. Biol. Evol. 1987, 4, 203–221. [Google Scholar] [CrossRef]
- Schlötterer, C.; Tautz, D. Slippage synthesis of simple sequence DNA. Nucleic Acids Res. 1992, 20, 211–215. [Google Scholar] [CrossRef]
- Gusa, A.; Jinks-Robertson, S. Mitotic Recombination and Adaptive Genomic Changes in Human Pathogenic Fungi. Genes 2019, 10, 901. [Google Scholar] [CrossRef]
- Verweij, P.E.; Zhang, J.; Debets, A.J.; Meis, J.F.; van de Veerdonk, F.L.; Schoustra, S.E.; Zwaan, B.J.; Melchers, W.J. In-host adaptation and acquired triazole resistance in Aspergillus fumigatus: A dilemma for clinical management. Lancet Infect. Dis. 2016, 16, e251–e260. [Google Scholar] [CrossRef]

| STR 3 * | STR 4 * | ||||||
|---|---|---|---|---|---|---|---|
| Type | Number | 3A | 3B | 3C | 4A | 4B | 4C |
| Ancestor | TR34/L98H | 31 | 9 | 8 | 6 | 8 | 19 |
| Evolved | TR343/L98H | 31 | 9 | 8 | 6 | 8 | 19 |
| MIC (µg/mL) | ||||
|---|---|---|---|---|
| Isolate Code | Genotype | ITR | VOR | POS |
| V30–40 | TR34/L98H | >16 | 4 | 0, 5 |
| v284–37 | TR343/L98H | >16 | >16 | >8 |
Publisher’s Note: MDPI stays neutral with regard to jurisdictional claims in published maps and institutional affiliations. |
© 2020 by the authors. Licensee MDPI, Basel, Switzerland. This article is an open access article distributed under the terms and conditions of the Creative Commons Attribution (CC BY) license (http://creativecommons.org/licenses/by/4.0/).
Share and Cite
Zhang, J.; Zoll, J.; Engel, T.; van den Heuvel, J.; Verweij, P.E.; Debets, A.J.M. The Medical Triazole Voriconazole Can Select for Tandem Repeat Variations in Azole-Resistant Aspergillus Fumigatus Harboring TR34/L98H Via Asexual Reproduction. J. Fungi 2020, 6, 277. https://doi.org/10.3390/jof6040277
Zhang J, Zoll J, Engel T, van den Heuvel J, Verweij PE, Debets AJM. The Medical Triazole Voriconazole Can Select for Tandem Repeat Variations in Azole-Resistant Aspergillus Fumigatus Harboring TR34/L98H Via Asexual Reproduction. Journal of Fungi. 2020; 6(4):277. https://doi.org/10.3390/jof6040277
Chicago/Turabian StyleZhang, Jianhua, Jan Zoll, Tobias Engel, Joost van den Heuvel, Paul E. Verweij, and Alfons J. M. Debets. 2020. "The Medical Triazole Voriconazole Can Select for Tandem Repeat Variations in Azole-Resistant Aspergillus Fumigatus Harboring TR34/L98H Via Asexual Reproduction" Journal of Fungi 6, no. 4: 277. https://doi.org/10.3390/jof6040277
APA StyleZhang, J., Zoll, J., Engel, T., van den Heuvel, J., Verweij, P. E., & Debets, A. J. M. (2020). The Medical Triazole Voriconazole Can Select for Tandem Repeat Variations in Azole-Resistant Aspergillus Fumigatus Harboring TR34/L98H Via Asexual Reproduction. Journal of Fungi, 6(4), 277. https://doi.org/10.3390/jof6040277

